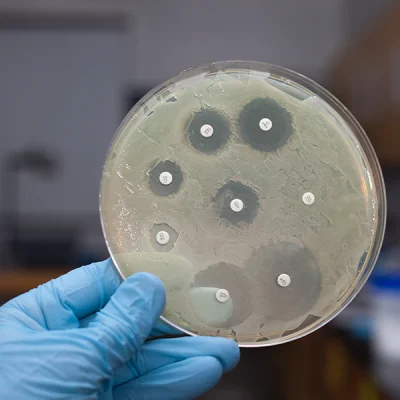
Fortalecimiento de la gobernanza de la resistencia antimicrobiana en Europa

La resistencia antimicrobiana ocurre cuando bacterias, virus u otros microorganismos dejan de responder a los medicamentos diseñados para eliminarlos, como los antibióticos. Esto hace que infecciones comunes sean más difíciles de tratar. En Europa, alrededor de 35.000 personas mueren cada año por infecciones resistentes a los antibióticos.
En este contexto, el estudio revisa y evalúa la situación de la gobernanza y cómo afectan a este desafío diferentes factores de cada país. Además, defiende el enfoque «Una salud», que afirma que para frenar la resistencia antimicrobiana se necesita colaboración entre sectores de salud humana, salud animal, agricultura, medio ambiente y políticas públicas. Es decir, es necesario abordar la resistencia desde múltiples fuentes: mejores antibióticos, uso responsable en humanos y animales, vigilancia, higiene, educación pública y control ambiental.
Las barreras frente a este reto incluyen recursos limitados, falta de coordinación entre sectores y liderazgo fragmentado, lo que reduce la eficacia de las acciones, aunque casi todos los países europeos cuentan con planes nacionales en este ámbito. Para mejorar la gobernanza, el estudio sugiere optimizar la coordinación regional, reforzar los sistemas de vigilancia, integrar políticas y promover la concienciación.